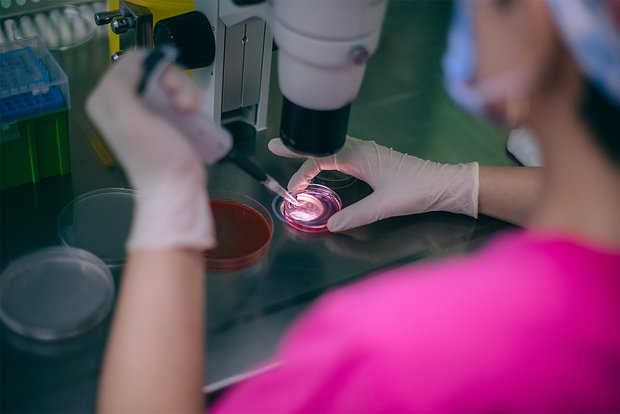

В Англии нашли клад серебра времен Римской империиБританские археологи наткнулись на клад из 16 серебряных динариев эпохи Римской империи. Находку сделали недалеко от деревни Бартон-Бендиш в графстве Норфолк на востоке Англии. Создан новый способ поиска следов воды и жизни на других планетахМеждународная группа ученых из США и Венгрии разработала новый подход к изучению поверхностей планет. Они выяснили, что разломы на Земле, Марсе и любых других каменистых мирах следуют определенным закономерностям. На Марсе нашли свидетельства существования теплой и влажной среды в прошломАмериканские ученые из Университета Пердью при участии коллег из других стран нашли доказательства того, что в прошлом Марс был теплой и влажной планетой. В Танзании нашли древнейшие костяные орудия возрастом 1,5 миллиона летФранцузские археологи из Университета Бордо нашли в Танзании древнейшие костяные орудия в мире возрастом около 1,5 млн лет. Татуировки признали причиной развития рака кожи и лимфомыТатуировки могут повышать риск развития рака кожи и лимфомы. К такому выводу пришли исследователи Университета Южной Дании и Хельсинкского университета, проанализировав данные 5900 близнецов. Воскрешая мамонтов: в США вывели мышей с шерстью вымерших млекопитающихИсследователи из американской биотехнологической и генно-инженерной компании Colossal Biosciences считают, что сделали серьезный шаг на пути к воссозданию шерстистого мамонта – животного вымершего несколько тысяч лет назад. Выбрав свой путь, они последовательно двигаются к заветной цели. В Китае нашли гигантского ядовитого скорпиона, жившего 125 млн лет назадУченые из Нанкинского института геологии и палеонтологии Китайской академии наук обнаружили окаменевшие останки гигантского ядовитого скорпиона, жившего 125 млн лет назад в меловом периоде. Дождь и снег дают надежду на ликвидацию самого сильного лесного пожара в Японии за последние 50 летВ Японии продолжается борьба с самым масштабным лесным пожаром за последние полвека. Выявлена связь между качеством спермы и продолжительностью жизниМужчины с более высоким качеством спермы живут дольше. К такому выводу пришли исследователи Копенгагенского университетского госпиталя, проанализировав данные 78 000 человек за 50 лет Курение назвали причиной распространения смертельно опасных бактерийТоксичные вещества из сигаретного дыма и окурков способствуют росту и распространению устойчивых к антибиотикам бактерий, угрожая как экологии, так и здоровью курильщиков. Участник секретного проекта Пентагона сообщил о гигантской пирамиде на МарсеУчастник секретного проекта Пентагона «Звездные врата» Джо Макмонигл заявил, что узнал о судьбе древних обитателей Марса с помощью телепатии. Как выбрать лучшую компанию по продвижению сайтовКак выбрать надежную компанию по продвижению сайтов? В этой статье мы расскажем, на что обратить внимание, как избежать ошибок и где искать проверенные рейтинги специалистов Раскрыта новая природа гравитацииФизики предложили новый взгляд на гравитацию, объединив ее с квантовой механикой через понятие энтропии. Работа профессора Гинестры Бьянкони из Лондонского университета Куин Мэри, опубликованная в Physical Review D, может приблизить ученых к созданию единой теории квантовой гравитации. Координатор лечения: в стоматологии - комфорт, забота и эффективность.Кто такой координатор лечения в клинике «Медалист» и как он помогает пациентам? Узнайте, как персональный менеджер организует лечение, контролирует сроки, поддерживает связь 24/7 и делает Мы привыкли к персональным менеджерам в банках и автосалонах, но теперь такой помощник есть и в стоматологии. Его главная задача – обеспечить пациенту комфортное сопровождение на протяжении всего лечения.комфортным и понятным.
259
Археологи нашли загадочные человеческие фигурыНа вершине древней пирамиды в Эль-Сальвадоре исследователи обнаружили пять керамических фигурок, предположительно использовавшихся в ритуалах. Интерактивное ТВ в эко-отеле: гармония технологий и природыЭко-отели предлагают гостям уникальный опыт, основанный на принципах развития и гармонии с природой. В такой концепции важна каждая деталь, и интерактивное телевидение гостиницы играет значительную роль в создании комфортной и экологичной среды.
219
Путешествия
Ученые раскрыли, как достичь счастья в жизниУченые из Университета Торонто в Скарборо установили, что «погоня» за счастьем и попытки взять все аспекты жизни под контроль приводят к истощению умственной энергии и ухудшению психического благополучия. Как Revit способствует повышению надежности зданийВ статье рассматривается, как Autodesk Revit улучшает надежность зданий с помощью трехмерного моделирования, управления данными и оптимизации проектирования, снижая риски и затраты. Гороскоп на 7 марта 2025 года для всех знаков зодиакаАстрология — это не просто увлечение, а целая наука, изучающая влияние небесных тел на человеческую жизнь. 7 марта года станет важной вехой для многих знаков зодиака. С чего начать бизнес в сфере SEO - пошаговое руководствоС чего начать бизнес в сфере SEO - пошаговое руководство. Рассматриваем подробно, как начать свой проект, на какие инструменты обратить внимание и как развиваться в данной отрасли самостоятельно. Как облагородить захоронение: варианты оформленияПосле смерти человека его родные и близкие стараются благоустроить место захоронения, чтобы периодически посещать его, сохраняя память об усопшем.
396
Другое
|